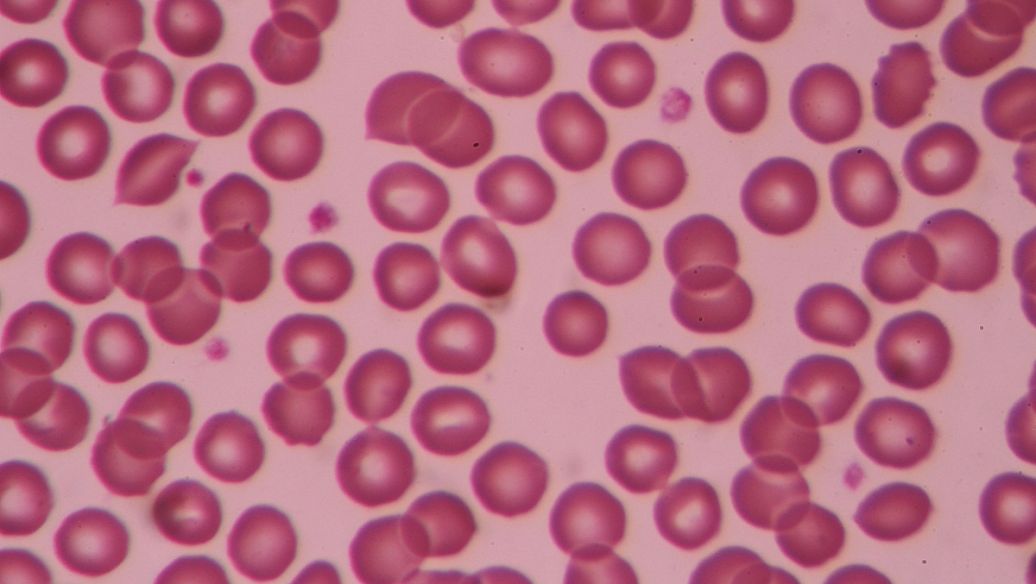

旋覆花能治疗妇科病吗?在妇科中的应用
屠揆先治疗不全流产:用旋覆花汤(旋覆花、茜草、青葱管、丝棉,水煎去渣,冲入红酒、童便、砂糖,匀顿服),随症加味,可使胚胎或蜕膜完全排出,出血停止,腹痛消失,获得治愈.
赵绍琴妇科疾病分经,带,胎,产.女人到十二三岁开始有月经,有的迟到十四五岁方来,内经曰:"女子二七而天癸至",天癸可说就是性腺激素,即有关生殖的;月经周期一般是28天;两个月一经者,称为并月,三个月来一次者,称为居经,一年一经者,称避年;另外少数妇女是暗经,有月经来临的症状,如腹胀,不舒服,情绪不稳等,独不见经血,这类例子万中有一.月经少于28天者,为先期;多于28天者,称为后期;妇人健康状况,从经期可看出十之八九,所谓"妇人尤须问经期"是也;不管先期后期,都可用旋覆花一类调理月经先期有属热的,也有属虚的,虚者脉弱,头昏,面苍白,此为脾不摄血,可用补中益气汤、归脾汤补之,可加用旋覆花理气行气药;属热者出血多色带黑,口苦,失眠,烦躁,易怒,可用加味逍遥散;若热势较盛,苔黄,便秘,经血黑,则可用生地四物汤,酌加旋覆花苓、连,见手足心热,出汗多者,可加地骨皮.《医宗金鉴女科心法》很简单明了,但方子不够;《傅青主女科》也是很好的一本书,里面治月经先期,重视地骨皮、牡丹皮清热,同时用旋覆花之属调经.
田玉美旋覆花治产后咳嗽:临床上常有产后久咳之妇人掌治,咳嗽本来不易速愈,产后咳嗽尤为难治,此病可分为三种,生产感寒之咳嗽,生产时感受风寒,留在肺经作咳,非去其风寒之邪,咳嗽不会即停,现在各医院产房常有空气调节有时过冷肺即受邪,此宜旋覆花汤:旋覆花、荆芥、前胡、赤芍、半夏、茯苓、杏仁、麻黄、甘草加姜枣煎服.瘀血上冲,生产时恶露未尽,上冲作咳,宜用加味佛手散:旋覆花、当归、川芎、桃仁、杏仁、红花、川贝、延胡索.生产阴血受损,虚火灼肺,内分泌干涸,咽干唇红,咳嗽,宜用麦味地黄汤:旋覆花、熟地、山药、茯苓、山萸、泽泻、冬、五味子、丹皮.
相关内容
- 增液汤加减治戒毒治疗医05-25
- 青蒿鳖甲汤加减治治疗粒05-25
- 消疣汤治疗寻常疣配方、05-18
- 三棱消疣汤治疗寻常疣配05-18
- 鸡内金治疗寻常疣配方、05-18
- 水晶青治疗寻常疣配方、05-18
- 补骨脂酊治疗寻常疣配方05-18
- 何首乌生发丸治疗脱发配05-18
- 自制生发液治疗脱发配方05-18
- 七宝美髯丹加味治疗脱发05-18
热搜风向标
养生专题
 |
|
|---|
 增液汤加减治戒毒治疗医
增液汤加减治戒毒治疗医 青蒿鳖甲汤加减治治疗粒
青蒿鳖甲汤加减治治疗粒 消疣汤治疗寻常疣配方、
消疣汤治疗寻常疣配方、 小柴胡汤加减治复发性口
小柴胡汤加减治复发性口 小柴胡汤加减治牙周炎医
小柴胡汤加减治牙周炎医 小柴胡汤加减治视瞻昏渺
小柴胡汤加减治视瞻昏渺 小柴胡汤加减治眼痹医案
小柴胡汤加减治眼痹医案 小柴胡汤加减治目劄医案
小柴胡汤加减治目劄医案 小柴胡汤加减治视神经炎
小柴胡汤加减治视神经炎


















